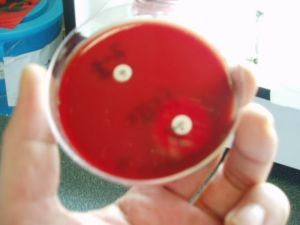
肺炎鏈球菌
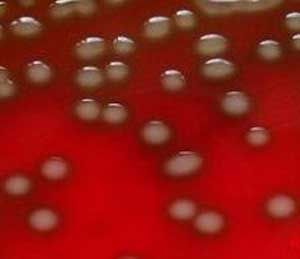
肺炎鏈球菌

簡介
 肺炎鏈球菌
肺炎鏈球菌肺炎鏈球菌簡稱肺炎球菌,在自然界中分布廣泛,可以在5-10%的健康成人及20-40%孩童的鼻咽內發現,在某一些環境,尤其是一些經常與人接觸的地方(如醫院或軍營),可以發現更多的數量。多數不致病或致病力很弱,少數致病力較強,其能否致病與莢膜有密切關係,因莢膜能抵抗人體內吞噬細胞的吞噬作用而大量繁殖,是細菌性大葉性肺炎的主要病原體。
歷史
作為一種重要的人類病因,肺炎鏈球菌於1880年代已被發現能引致肺炎,也是體液免疫研究的對象。
肺炎鏈球菌於1926年的最初名字是肺炎雙球菌(學名Diplococcuspneumonia),因它在革蘭氏染色中的特徵。
1974年,因它在液體媒介中鏈的長成,而被重新命名為肺炎鏈球菌。因它是肺炎的病原因子,一般都會稱它為肺炎球菌。
生物學性狀
形態
肺炎鏈球菌
肺炎鏈球菌染色革蘭染色陽性,菌體呈矛頭或瓜籽仁狀,直徑約1um,常以鈍端相對、尖端向外成雙排列,無鞭毛,無芽孢。在機體內或含血清的培養基上有較厚的莢膜,人工培養後莢膜逐漸消失。革蘭染色時莢膜不著色,表現為菌體周圍透明環。菌體衰老時,或由於自溶酶的產生將細菌裂解後,可呈革蘭染色陰性。
培養特性
需氧或兼性厭氧。營養要求較高,最適溫度為37℃,最適pH7.4—7.8,在血液或血清的培養基中才能生長,形成細小圓形、隆起、表面光滑、灰白色、濕潤並有草綠色溶血環的菌落,與甲型溶血性鏈球菌很相似。
若孵育時間大於48h,肺炎鏈球菌產生的自溶酶,使菌體逐漸溶解,菌落中央下陷呈臍狀。在血清肉湯中,初期呈混濁生長,稍久細菌的自溶酶使細菌自溶,培養液漸變澄清。
生化反應
可分解葡萄糖、麥芽糖、乳糖、蔗糖等,產酸不產氣。對菊糖發酵反應不一,大多數新分離株為陽性,故菊糖在鑑別肺炎鏈球菌與甲型溶血性鏈球菌時僅作參考。肺炎鏈球菌自溶酶可被膽汁或膽鹽激活,使細菌加速溶解,故常用膽汁溶菌試驗與甲型鏈球菌區別。
抗原構造與分型
1、莢膜多糖抗原:存在於肺炎鏈球菌莢膜中。根據莢膜多糖抗原性的不同,可將肺炎鏈球菌分為84個血清型,分別以1、2、3、4等表示之,個別型還可分成不同的亞型,如7A、7B、7C和7D亞型。其中有20多個型別可引起疾病,以1-3型致病力較強。
2、菌體抗原
(1)、多糖:存在於肺炎鏈球菌細胞壁中,為各型菌株所共有,具有種特異性。C多糖可被血清中C-反應蛋白沉澱。在Ca2+存在時,C多糖可與血清中一種稱為C反應蛋白(CRP)結合,激活補體,促進吞噬細胞的吞噬功能。正常人血清中CRP含量極微。當急性炎症時含量劇增,故用C多糖來檢測CRP對活動性風濕病及急性炎症性疾病的診斷有一定意義。
(2)、M蛋白型特異抗原。
抵抗力
較弱,加熱56℃15-30min即被殺死。對一般消毒劑敏感,在3%苯酚或0.1%升汞溶液中1—2min即死亡,對肥皂也很敏感。有莢膜的肺炎球菌在乾痰中可存活1—2個月。對青黴素、紅黴素、林可黴素等敏感。
流行病學
傳播途徑
通過人傳人的飛沫感染而傳播。
易感人群
 肺炎鏈球菌
肺炎鏈球菌任何人,皆可被肺炎鏈球菌感染,但以下3類人士特別容易受到侵襲:
65歲以上人士;
5歲以下兒童,特別是2歲以下的幼童;
高危人群,如長期病患者等。
以年齡層論,受肺炎鏈球菌侵襲,引致侵犯性肺炎鏈球菌疾病的最高危者,是5歲以下的小兒,特別是2歲以下的幼童。一旦受到侵襲,死亡率最高的是年長的老人家及有長期病患的高危人群。
中國2011年婦幼衛生事業發展報告指出,肺炎位列中國五歲以下兒童死因的第二位,在重症肺炎中,約有50%是由肺炎鏈球菌引起的。肺炎鏈球菌不僅是小兒肺炎的主要“元兇”,也是引起肺炎死亡的重要病原。嬰兒從6月齡起母傳抗體逐漸消失,因此6月齡到2歲是兒童侵襲性肺炎鏈球菌性疾病發病率最高的時期。
流行季節
季節性肺炎鏈球菌感染最常發生在冬季和初春,這個時段也正是傷風感冒等上呼吸道感染的高峰期。
致病性
致病物質
1、莢膜:是肺炎鏈球菌主要的致病因素。有莢膜的肺炎球菌可抵抗吞噬細胞的吞噬,有利於細菌在宿主體內定居並繁殖。
2、肺炎鏈球菌溶血素:高濃度時對實驗動物有致死性。對人的致病機制尚待確定。
3、紫癜形成因子:注入家兔皮內,可產生紫癜及出血點並伴有內臟出血。紫癜形成因子與人類肺炎球菌感染間的關係尚不明確。
4、神經氨酸酶:在新分離株中發現,能分解細胞膜糖蛋白和糖脂的N-乙醯神經氨酸,與肺炎鏈球菌在鼻咽部和支氣管黏膜上定植、繁殖和擴散有關。
所致疾病
 肺炎
肺炎1、主要引起人類大葉性肺炎:
(1)、成人75%的肺炎鏈球菌肺炎及50%以上嚴重的肺炎鏈球菌菌血症是由1—8型、12、14及16型肺炎鏈球菌引起,以1、2、3型最多見,其中3型肺炎鏈球菌因產生大量莢膜,毒力強,病死率高。
(2)、兒童大葉性肺炎以1、6、14和19型多見,其中以14型最常見。
2、其他疾病
肺炎鏈球菌還會導致不同種類的疾病,包括有急性鼻竇炎、中耳炎、腦膜炎、骨髓炎、膿毒性關節炎、心內膜炎、腹膜炎、心包炎、蜂窩組織炎及腦膿腫。
致病機理
該菌常寄居在正常人口腔及鼻咽部,一般不致病,只形成帶菌狀態。但當機體免疫力下降時可致病。臨床症狀為突然發病,高熱、寒戰、胸膜劇烈疼痛、咳鐵鏽色痰。10%—20%的患者可於高熱期伴發菌血症。其病理表現主要是最初肺泡內有大量纖維蛋白滲出液,繼之是紅細胞和白細胞向肺泡內滲出,最終導致病變部位肺組織實變。病變通常僅累及單個肺葉,故稱為大葉性肺炎。肺炎鏈球菌也可侵入機體其他部位,引起胸膜炎、中耳炎、乳突炎、心內膜炎及化膿性腦膜炎等,尤其是呼吸道病毒感染者或嬰幼兒、老年體弱者。
免疫性
肺炎鏈球菌感染後,機體可建立較牢固的型特異性免疫,故同型病菌的二次感染少見。其機制主要是機體在發病後5—6天,可產生莢膜多糖型特異抗體,與莢膜結合後,肺炎鏈球菌易被機體吞噬細胞吞噬殺滅;補體在清除病原菌過程中亦有調理作用,當抗原抗體複合物與補體結合後,可增強吞噬細胞對病原菌的吞噬。1、4和25型莢膜多糖尚能直接激活補體的旁路途徑,這在特異性抗體未產生前,對入侵病菌的殺滅具有重要意義。
微生物學檢查
標本
根據感染部位不同採取不同標本,如痰液、膿液、血液、腦脊液等。
直接塗片鏡檢
對痰、膿或腦脊液沉澱物標本,可塗片進行革蘭染色鏡檢,若發現典型的成雙排列、有莢膜的革蘭陽性球菌,結合臨床症狀可做初步診斷。
分離培養與鑑定
肺炎鏈球菌
肺炎鏈球菌將痰或膿液直接接種於血瓊脂平板上,37℃孵育24h後,挑選溶血的可疑菌落做進一步鑑定。血液及腦脊液先在血清肉湯培養基中增菌後,接種到血瓊脂平板上分離培養並鑑定。
1、與其他致病菌鑑別
肺炎鏈球菌的鑑定主要應與甲型溶血性鏈球菌鑑別。其中以膽汁溶菌試驗、菊糖發酵和奧普托辛試驗最為常用。必要時可做小鼠毒力試驗。在上述試驗中,肺炎鏈球菌均為陽性,而甲型溶血性鏈球菌為陰性。
2、肺炎鏈球菌型別鑑定
(1)莢膜腫脹試驗:亦稱為Quellug試驗。新鮮標本懸液與等量不稀釋的肺炎球菌分型診斷血清混合後,覆以蓋玻片,油鏡下觀察。標本中肺炎球菌若與同型免疫血清相遇,莢膜將顯著增大。
(2)凝集試驗:將可疑肺炎球菌與已知標準分型血清做玻片凝集試驗,若細菌凝集成堆,為同型肺炎球菌。
防治原則
多價肺炎鏈球菌莢膜多糖疫苗對預防肺炎鏈球菌感染有較好效果。21世紀初,這種多價疫苗已包括肺炎鏈球菌的23個型。對肺炎鏈球菌感染的治療,因人群肺炎鏈球菌感染的菌型在不斷變遷。且耐藥菌株日益增多,因此需加強肺炎鏈球菌的菌型監測,在治療前做常規藥物敏感試驗,根據藥敏試驗,選用敏感的抗生素(如青黴素、林可黴素、四環素等)。
菌物界(五)
| “菌物界”這個名詞是我國學者裘維蕃等於1990年提出的,並已得學術界的一定支持,這是指與動物界,植物界相併列的一大群無葉綠素,依靠細胞表面吸收有機養料,細胞壁一般還有幾丁質的真核微生物。一般包括真菌,粘菌和假菌(卵菌等)3類。 |
盤點鮮為人知的微生物
| 微生物是一切肉眼看不見的或看不清的微小生物的總稱。包括細菌、病毒、真菌以及一些小型的原生動物、顯微藻類等在內的一大類生物群體,它個體微小,卻與人類生活關係密切。 |

